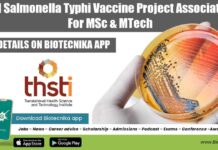
THSTI Salmonella Typhi Vaccine Project Associate Job For MSc & MTech THSTI Jobs 2022

Govt CDSCO MSc, PhD, BTech & MTech Biotech, Mol Bio, Biochem Job With Pay...
Govt CDSCO Research Jobs For MSc, PhD, BTech & MTech Biotech, Mol Bio, Biochem Job With Pay Upto Rs. 84,000 pm
Govt CDSCO Research Jobs...
AIIMS Senior Research Fellow Job For MSc Life Sciences, Applications Invited
AIIMS Delhi MSc SRF Job Opening For Life Sciences, Applications Invited
AIIMS Delhi MSc SRF Job Opening For Life Sciences, Applications Invited. AIIMS New Delhi...
CSIR-CFTRI BTech & MSc Research Fellow Recruitment, Online Application Process
CFTRI BTech Biotech JRF, MSc Biochem, Mol Bio & Microbiology Apply
CFTRI BTech Biotech JRF, MSc Biochem, Mol Bio & Microbiology Apply. CSIR-CFTRI Job Opening....
Syngene MSc, MTech & BTech Biotechnology Research Associate Recruitment
Syngene Biotechnology Associate Job For Candidates With 1-6 Years Exp, Apply Online
Syngene Biotechnology Associate Job For Candidates With 1-6 Years Exp, Apply Online. MSc,...
Visiting Students’ Research Programme (VSRP-2023) – Summer Research Programme With Monthly Stipend
TIFR Hyderabad Summer Research Programme - Visiting Students' Research Programme (VSRP-2023)
TIFR Hyderabad Summer Research Programme - Visiting Students' Research Programme (VSRP-2023). TIFR Hyderabad Semester...
CSIR NET Exam 2023 Preparation Checklist For Getting Top JRF & LS Rank
CSIR NET 2023 Preparation Tips & Checklist for Life science exam
The Council of Scientific and Industrial Research (CSIR) National Eligibility Test (NET) is a...
Pursue Your PhD In Singapore With SINGA 2024 Scholarship
SINGA 2024: Singapore International Graduate Award
SINGA 2024: Singapore International Graduate Award. Interested candidates from all over the globe are eligible to apply for the...
DBT-Research Associateship Programme in Biotech & Life Sciences 2022-2023 (Call-II)
DBT RA Programme 2022-2023 - DBT-Research Associateship Programme 2022
DBT RA Programme 2022-2023 - DBT-Research Associateship Programme 2022. DBT-Research Associateship Programme in Biotech & Life...
How To Earn Crores in Biotech Sector – Bio Entrepreneurship National Workshop 2023
How To Earn Crores in Biotech Sector - Bio Entrepreneurship National Workshop
Are you ready to be a part of the biotech revolution and earn...
WISE Post-Doctoral Fellowship (WISE-PDF) – Call For Proposals Open!
WISE Post-Doctoral Fellowship (WISE-PDF) - Call For Proposals Open!
WISE Post-Doctoral Fellowship (WISE-PDF) - Call For Proposals Open! DST is starting new program 'WISE-PDF' for...
Biotecnika Times Newsletter 30.01.2023 IISER PhD Admission, CBMR Research Jobs
Biotecnika Times Newsletter 30.01.2023 IISER PhD Admission, CBMR Research Jobs
IISER Pune PhD Admissions 2023 (August) - Biology PhD Programme
IISER Pune PhD 2023 Admissions (August)...
CBMR Research Associate Jobs For PhD Biotech, Life Sciences, Biology, Biochemistry
CBMR Research Associate Jobs For PhD Biotech, Life Sciences, Biology, Biochemistry
CBMR Research Associate Jobs For PhD Biotech, Life Sciences, Biology, Biochemistry. Centre of Biomedical...
NIANP Senior Research Fellow Job Opening For Life Sciences, Biochem
NIANP Research Job Opening For Cell Biology, Biotech, Microbiology
NIANP Research Job Opening For Cell Biology, Biotech, Microbiology. Bengaluru jobs. NIANP Bengaluru vacancies. MSc Cell...
MAHE Junior Research Fellow Job For MSc Botany, Plant Sciences & Biotech
MAHE JRF Post For MSc Botany, Plant Sciences & Biotechnology
MAHE JRF Post For MSc Botany, Plant Sciences & Biotechnology. Manipal Academy of Higher Education...
ICMR Delhi Life Sciences Project Scientific Support Job Opening, Attend Walk-In
ICMR Delhi Life Sciences Project Scientific Support Job Opening, Attend Walk-In. MSc, PhD Life Sciences job opening. Interested and eligible applicants can check out...